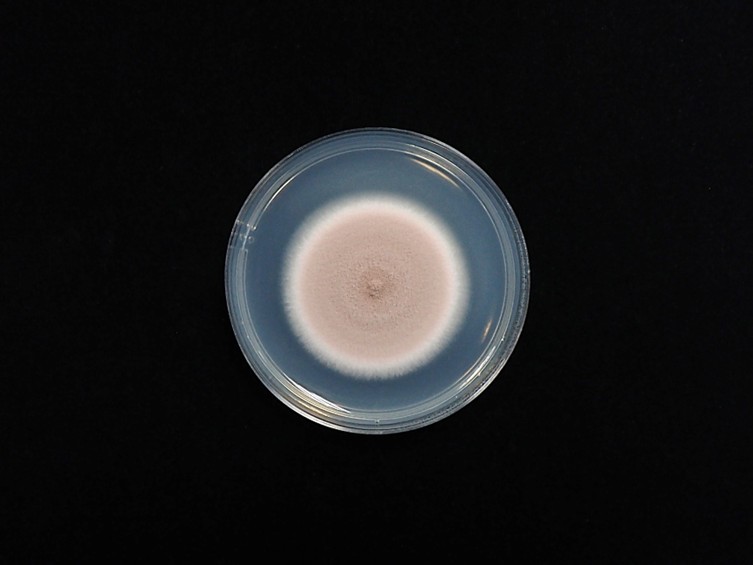

Holotype:
ex-type living culture CBS 284.36.
Habitat:
Leaf litter, soil.
Host:
Cydnid bugs (Hemiptera, Cydnidae), soil.
Description:
 Synnema arising from head region of host, yellowish to brownish, 15–60 mm long, 0.5–2 mm wide. Synnema pink to purple due to the production of conidia.
Synnema arising from head region of host, yellowish to brownish, 15–60 mm long, 0.5–2 mm wide. Synnema pink to purple due to the production of conidia.
Culture characteristics:
Colonies on PDA attaining a diam 20 in 10 d, floccose, at first white but turning pink or pinkish purple due to the colour of
PDA attaining a diam 20 in 10 d, floccose, at first white but turning pink or pinkish purple due to the colour of  conidia. Vegetative hyphae smooth, septate, hyaline.
conidia. Vegetative hyphae smooth, septate, hyaline.  Conidiophores form verticillate branches with terminal whorls of three to five phialides or singly arising from hyphae. Phialides awl-shaped, cylindrical ellipsoidal or swollen basal portion into distinct neck, 6–10 × 2–3 μm. Conidia subglobose with apiculate base or limoniform, 2–4 × 2–3 mm, dry, in long chain.
Conidiophores form verticillate branches with terminal whorls of three to five phialides or singly arising from hyphae. Phialides awl-shaped, cylindrical ellipsoidal or swollen basal portion into distinct neck, 6–10 × 2–3 μm. Conidia subglobose with apiculate base or limoniform, 2–4 × 2–3 mm, dry, in long chain.
Reference:
Luangsa-Ard J, Houbraken J, van Doorn T, et al. (2011). Purpureocillium, a new genus for the medically important Paecilomyces lilacinus. FEMS microbiology letters 321: 141–149.
DOI: https://doi.org/10.1111/j.1574-6968.2011.0232Species |
Strain |
Compound |
Pubchem CID |
Biological activity |
Reference |
|---|
|
Strain |
MH855800 |
|---|---|
| CBS 284.36 | - |